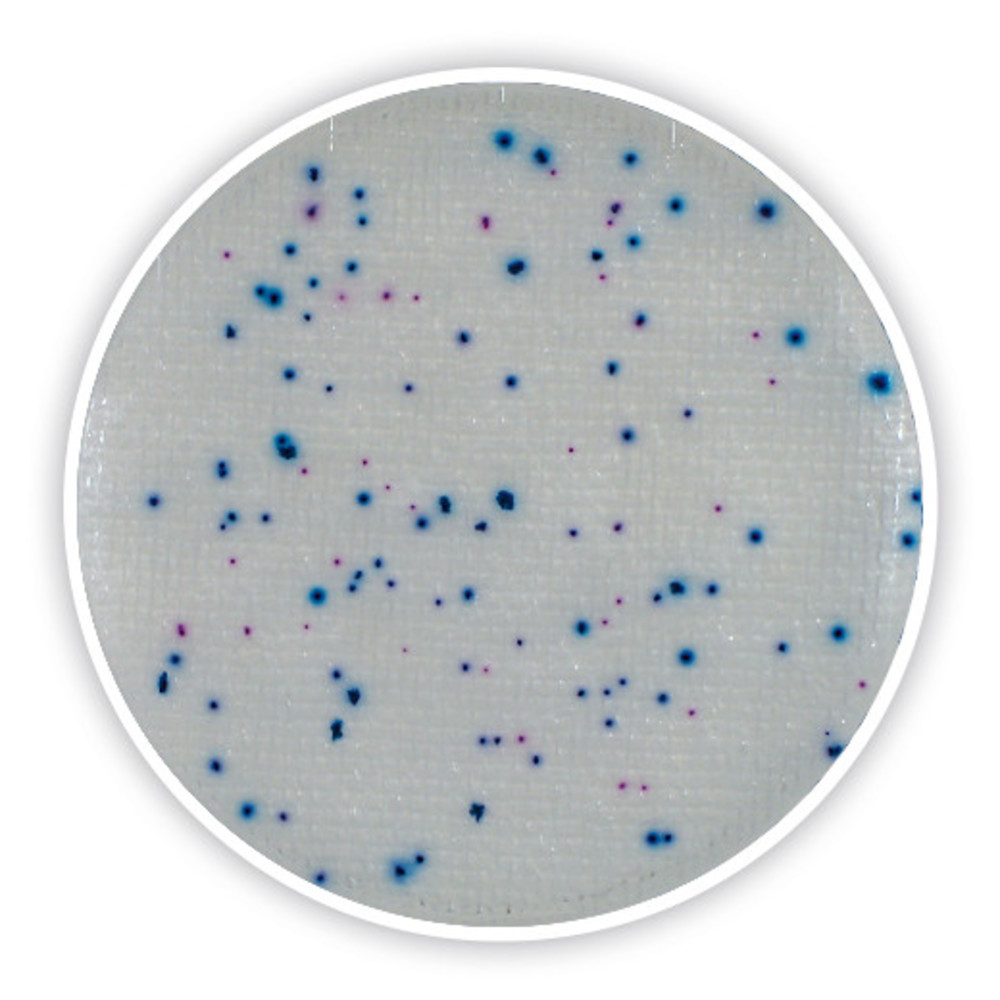
BOITES DE CONTACT PRE-COULEES (Compact Dry ETC) pack de 40

BOITES DE CONTACT PRE-COULEES (Compact Dry ETC) pack de 40
NST
CWATTESTNUPD
Article valide
Code de Compte:
61010
HS Code:
382200
Last Updated on:
13/11/2025, 22:58:53